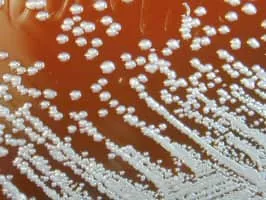
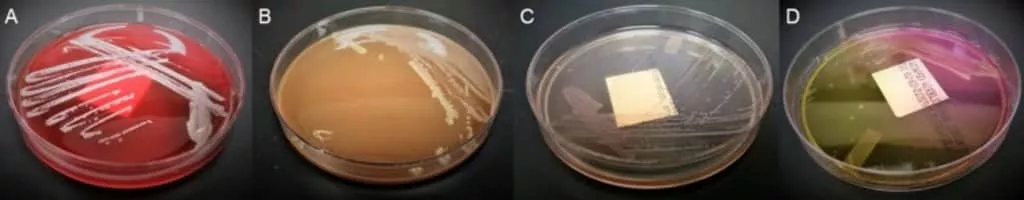

Burkholderia
| Use attributes for filter ! | |
| Class | Betaproteobacteria |
|---|---|
| Scientific name | Burkholderia |
| Rank | Genus |
| Order | Burkholderiales |
| Phylum | Proteobacteria |
| Higher classification | Burkholderiaceae |
| Lower classifications | Burkholderia cepacia |
| Date of Reg. | |
| Date of Upd. | |
| ID | 2442427 |
About Burkholderia
Burkholderia is a genus of Proteobacteria whose pathogenic members include the Burkholderia cepacia complex which attacks humans and Burkholderia mallei, responsible for glanders, a disease that occurs . . .